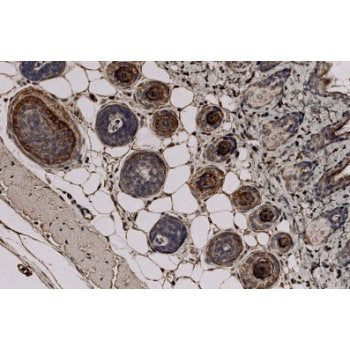

Shigella dysenteriae Monoclonal Antibody [M81]
| Product Code: | IQ428 |
| Reactivity: | Bacteria |
| Application: | ICC/IF |
Sigma 54 Monoclonal Antibody [33.7]
| Product Code: | IQ335 |
| Reactivity: | Escherichia coli , Bordetella pertussis |
| Application: | ELISA, WB |
SLC9A3R2 Monoclonal Antibody [32B6]
| Product Code: | IQ577 |
| Reactivity: | Human. Predicted to work with: Mouse, Rat |
| Application: | WB, IP |
| Citation Count: | 1 |
SMN/Gemin-1 Monoclonal Antibody [2B1]
| Product Code: | IQ202 |
| Reactivity: | Mouse, Human, Xenopus laevis |
| Application: | IHC-P, ICC/IF, ELISA, WB, IP, Flow Cyt |
| Citation Count: | 14 |
Spi2A Monoclonal Antibody [MoFo29.2]
| Product Code: | IQ318 |
| Reactivity: | Mouse |
| Application: | WB, IHC-P |
SUN1 Antibody
| Product Code: | IQ564 |
| Reactivity: | Human |
| Application: | WB, IP, ICC/IF |
| Citation Count: | 1 |
SUN2 Antibody
| Product Code: | IQ563 |
| Reactivity: | Mouse |
| Application: | WB, ICC/IF |
| Citation Count: | 1 |
TAP1 Monoclonal Antibody [53H8]
| Product Code: | IQ224 |
| Reactivity: | Human |
| Application: | ELISA, WB, IP, ICC/IF |
| Citation Count: | 1 |
TCR Alpha + TCR Beta Monoclonal Antibody [KJ1298]
| Product Code: | IQ381 |
| Reactivity: | Mouse |
| Application: | IP, ELISA, Inhibition Assay, Flow Cyt |
| Citation Count: | 1 |
Testosterone Monoclonal Antibody [FB83]
| Product Code: | IQ396 |
| Reactivity: | Human |
| Application: | IHC(P), ELISA, RIA |
Testosterone Monoclonal Antibody [R58]
| Product Code: | IQ395 |
| Reactivity: | Human |
| Application: | ELISA, RIA |
TGF beta1 Monoclonal Antibody [TB21]
| Product Code: | IQ159 |
| Reactivity: | Mouse, Rat, Sheep, Rabbit, Cow, Human, Mink |
| Application: | ELISA, IHC(Fr), IHC(P), WB |
| Citation Count: | 1 |
Transportin 1/MIP Monoclonal Antibody [D45]
| Product Code: | IQ223 |
| Reactivity: | Mouse, Rabbit, Human, Monkey |
| Application: | Flow Cyt, ICC/IF, IHC-P, ELISA, WB, IP |
| Citation Count: | 8 |
TRF1/TERF1 Monoclonal Antibody [3H11]
| Product Code: | IQ281 |
| Reactivity: | Human |
| Application: | ELISA, ICC/IF, WB, Flow Cyt |
Trichohyalin Monoclonal Antibody [AE15]
| Product Code: | IQ337 |
| Reactivity: | Mouse, Human |
| Application: | WB, IHC-Fr, IHC-P |
| Citation Count: | 15 |
Upf1/Rent1 (pThr28) Antibody [P-CS-1]
| Product Code: | IQ653 |
| Reactivity: | Human |
| Application: | WB, IB, ELISA |
VEGF Monoclonal Antibody [VG76e]: Horseradish Peroxidase (HRP)
| Product Code: | IQ644HRP |
| Reactivity: | Human, Mouse, Marmoset |
| Application: | IHC-P, WB |
| Citation Count: | 1 |
Y14 Monoclonal Antibody [4C4]
| Product Code: | IQ220 |
| Reactivity: | Human, Xenopus laevis |
| Application: | Flow Cyt, IHC-P, ICC/IF, ELISA, WB, IP |
| Citation Count: | 7 |
- Previous
-
Page 15 of 15
-
Next